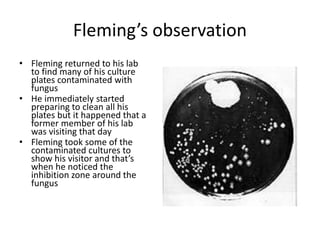
Fleming’s observation
• Fleming returned to his lab
to find many of his culture
plates contaminated with
fungus
• He immediately started
preparing to clean all his
plates but it happened that a
former member of his lab
was visiting that day
• Fleming took some of the
contaminated cultures to
show his visitor and that’s
when he noticed the
inhibition zone around the
fungus

The document reviews the history and mechanisms of β-lactam antibiotics, detailing their structure and classes, including penicillins, cephalosporins, carbapenems, and monobactams. It explains the discovery of penicillin by Alexander Fleming, subsequent developments by Howard Florey and Ernst Boris Chain, and advancements in antibiotic production and resistance. Moreover, it highlights the improvements in antibiotic formulations to enhance stability, broaden their spectrum of activity, and combat bacterial resistance.